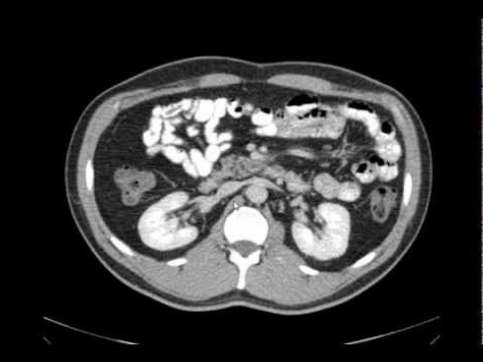
Corte Axial

UFTM - TC do Abdômen
Prof. Esp. Eduardo Felix
Tomografia Computadorizada do Abdômen: Aspectos Gerais
O que é a TC de Abdômen?
A tomografia computadorizada do abdômen é um exame de imagem que utiliza raios-X para criar imagens detalhadas em cortes transversais das estruturas abdominais, permitindo avaliação precisa de órgãos, vasos e tecidos.
Vantagens: Alta resolução espacial, aquisição rápida, capacidade de reconstruções multiplanares e avaliação com contraste.
Indicações Principais
Avaliação de causa indeterminada
Avaliação de lesões internas
Caracterização e estadiamento
Avaliação da aorta abdominal
Abscessos e processos inflamatórios
Esteatose, cirrose, tumores
Contraindicações
- Gravidez: Especialmente no primeiro trimestre (risco de radiação ao feto)
- Alergia ao contraste iodado: Em exames que necessitam de meio de contraste
- Insuficiência renal grave: Risco de nefropatia induzida por contraste
- Marcapasso: Em algumas situações específicas (avaliação individual)

Equipamento de TC (Fonte: Wikimedia Commons)
Anatomia do Abdômen na TC
Conhecimento anatômico detalhado é fundamental para a interpretação adequada das imagens de TC abdominal.
Órgãos Abdominais Principais
Fígado
Maior glândula do corpo, localizado no hipocôndrio direito
Pâncreas
Glândula mista localizada retroperitonealmente
Baço
Órgão linfoide localizado no hipocôndrio esquerdo
Rins
Órgãos pares localizados no retroperitônio
Estômago
Órgão digestivo localizado no epigástrio
Intestinos
Delgado e grosso (cólon)
Vasos Sanguíneos Principais
- Aorta abdominal: Principal artéria do abdômen
- Veia cava inferior: Principal veia do abdômen
- Artérias renais: Vascularização dos rins
- Veia porta: Drena sangue do trato gastrointestinal para o fígado
- Veia esplênica: Drena sangue do baço

Visualização anatômica do abdômen em tomografia computadorizada (Fonte: Radiology Key)
TC Convencional vs. Helicoidal
TC Convencional
- Aquisição corte a corte
- Maior tempo de exame
- Limitação em estudos dinâmicos
- Menor qualidade em reconstruções 3D
- Maior chance de artefatos por movimento
TC Helicoidal (Multidetectores)
- Aquisição contínua em espiral
- Tempo de exame reduzido
- Ideal para estudos com contraste
- Excelente qualidade em reconstruções 3D
- Menor dose de radiação
Vantagem da TC Helicoidal Multidetectores: Permite aquisições mais rápidas, com melhor resolução temporal e espacial, essencial para estudos angiográficos e de perfusão.

Metodos de aquisição Simgle e Helicoidal (Fonte: Wikimedia Commons)

Metodos de aquisição Multi-slice (Fonte: Wikimedia Commons)
Parâmetros Técnicos da TC Abdominal
Espessura de Corte
Varia de acordo com o fabricante, geralmente entre 1 a 10 mm. Para estudos abdominais de rotina, cortes de 3-5 mm são frequentemente utilizados.
Incremento
Distância entre cortes consecutivos, variando de 0 a 30 mm. Incrementos menores que a espessura do corte proporcionam sobreposição de imagens, melhorando reconstruções multiplanares.
Volume Helicoidal
Na TC helicoidal, a espessura de corte pode variar de 0,5 a 10 mm, com incremento de reconstrução de 0 a 30 mm, permitindo aquisições volumétricas do abdômen.
Avaliação de cálculos, sangramentos agudos e densificação basal
20-30 segundos pós-injeção - avaliação de vasos arteriais
60-70 segundos pós-injeção - avaliação de parênquima hepático
3-5 minutos pós-injeção - avaliação de estruturas venosas

Fases de aquisição de contraste (Fonte: Wikimedia Commons)
Posicionamento e Planejamento
Posicionamento do Paciente
- Decúbito dorsal (supino)
- Membros superiores posicionados acima da cabeça
- Inserção no gantry com a cabeça primeiro (FH) ou pés primeiro (FF)
- Uso de suportes laterais para estabilização
Planejamento do Exame
- Topograma: Imagens de perfil e anterior para planejamento
- FOV (Field of View): Do nível de T10 (cúpula diafragmática) até o ísquio
- Varredura: Geralmente no sentido caudo-cranial
- Windows (janelas): Partes moles para avaliação de órgãos sólidos
- Filtros: Partes Moles (B31s medium) e Osso (B70s sharp) quando necessário
- Espessura de corte: 1 mm para alta resolução
- Reconstruções: Coronal, sagital e 3D (VRT) quando necessário

Posição do paciente (Fonte: Wikimedia Commons)

Metodos de aquisição Simgle e Helicoidal (Fonte: Wikimedia Commons)
TC do Abdômen com Contraste
Protocolo de Administração
- Injeção: Preferencialmente com bomba de infusão para controle preciso
- Fluxo: 2,5 a 3 ml por segundo
- Volume: 1 a 2 ml/kg (máximo de 120 mL)
- Atraso de aquisição: 40 segundos após o término da injeção para fase portal
Indicações para Uso de Contraste
- Caracterização de massas e lesões
- Avaliação vascular (aneurismas, tromboses)
- Detecção de abscessos e processos inflamatórios
- Estadiamento de neoplasias
- Avaliação de órgãos parenquimatosos (fígado, pâncreas, baço, rins)
Precauções: Em pacientes com risco de nefropatia induzida por contraste, considerar hidratação prévia e uso de menor volume de contraste.
Aplicações Especiais da TC Abdominal
Urotomografia (TC Multidetectores)
Estudo específico do trato urinário, ideal para avaliação de:
- Cálculos renais e ureterais
- Tumores do trato urinário
- Anomalias congênitas
- Doenças inflamatórias
Avaliação de Oclusão Intestinal
A TC multidetectores é o método de escolha para:
- Diagnóstico de obstrução intestinal
- Identificação do nível e causa da obstrução
- Detecção de complicações (estrangulamento, isquemia)
- Avaliação de abdômen agudo

Exemplo de urotomografia por TC mostrando o trato urinário (Fonte: Radiographics)
Interpretação Básica de Imagens
Avaliação Sistemática
- Parede abdominal: Músculos, gordura subcutânea, pele
- Órgãos sólidos: Fígado, baço, pâncreas, rins
- Trato gastrointestinal: Estômago, intestino delgado, cólon
- Sistema vascular: Aorta, veia cava, vasos mesentéricos
- Espaços: Retroperitônio, cavidade peritoneal
- Estruturas ósseas: Vértebras, costelas, pelve
Achados Patológicos Comuns
- Hipodensos: Cistos, necrose, edema
- Hiperdensos: Calcificações, sangramento agudo, contraste
- Realce: Tumores, inflamações, infartos
- Ar: Pneumoperitônio, abscessos gasosos
- Líquido: Ascite, coleções

Metodos de aquisição Simgle e Helicoidal (Fonte: Wikimedia Commons)

Metodos de aquisição Simgle e Helicoidal (Fonte: Wikimedia Commons)

Metodos de aquisição Simgle e Helicoidal (Fonte: Wikimedia Commons)
Metodos de aquisição Simgle e Helicoidal (Fonte: Wikimedia Commons)

Metodos de aquisição Simgle e Helicoidal (Fonte: Wikimedia Commons)